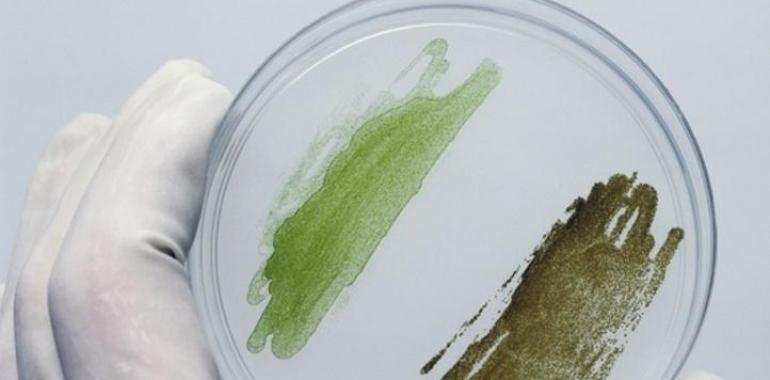

JPA/DICYT La Universidad de Salamanca ha diseñado un proyecto que pretende reducir las emisiones de dióxido de carbono (CO2) a la vez que se generan productos de valor añadido con utilidad en campos, ya que sus componentes son aprovechados por la industria farmacéutica y por el sector alimenticio. La clave está en las microalgas, organismos vegetales con una gran capacidad de absorción del gas de efecto invernadero y que ya están siendo muy utilizadas en muchos proyectos de I+D+i para diversas industrias. La producción de este cultivo tan especial en condiciones adecuadas tendría, por lo tanto, un doble objetivo.
"La idea es absorber CO2 debido al problema del efecto invernadero y el calentamiento global que provoca", explica en declaraciones a DiCYT Pedro José García Vara, alumnos de Ingeniería Química de la institución académica salmantina. "Hemos propuesto la utilización de microalgas porque son unos microorganismos con un potencial de absorción de CO2 muy alto y unas tasas de crecimiento entre cinco y seis veces superiores a cualquier otro vegetal que se cultiva, como el maíz", agrega.
Además, "es la única tecnología que permite la absorción real del CO2 porque en la actualidad se están implementando sistemas basados en aminas y carbonatos, pero en estos casos, se vuelven a disolver para su acumulación posterior y el rendimiento energético y de producción es negativo", señala. La idea pasaría por instalar una hipotética planta de este tipo junto a industrias o centrales térmicas que emitiesen grandes cantidades de CO2, de manera que éste podría ser aprovechado para el desarrollo de las microalgas, evitando que llegue a la atmósfera.
El proyecto, que ha estado financiado por el Programa de Prototipos Orientados al Mercado de la Universidad de Salamanca dentro del Proyecto de Transferencia de Conocimiento Universidad-Empresa (T-CUE) ha incluido el diseño de un fotobiorreactor para cultivar la microalga en condiciones óptimas, así como el diseño de una "refinería microalgal", que procesaría las microalgas para obtener los productos de valor añadido. Todo ello se completa con un análisis económico para analizar qué rentabilidad económica tendría esta idea si se pasa de este modelo experimental a la construcción real.
Alto valor proteico
En este sentido, hay que tener en cuenta que "los productos alimenticios y farmacéuticos a partir de estas microalgas tienen valor proteico 20 veces mayor que el maíz o la soja y hasta 400 veces mayor que el ganado vacuno por unidad de superficie empleada para ese propósito", comenta el investigador, que ha estado apoyado en la dirección de este proyecto por la científica del Departamento de Ingeniería Química y Textil Eva Martín del Valle.
Los datos indican que "para una planta de unas 200 hectáreas, la rentabilidad sería baja", reconoce, pero "la investigación con microalgas está en una fase muy inicial y su potencial podría duplicarse y triplicarse en el futuro". Para la absorción de CO2, por el momento sería sólo una solución parcial. "En el proyecto que hemos diseñado, la central térmica emitía anualmente cinco millones de toneladas de CO2 y nosotros podríamos absorber unas 6.000 toneladas, un porcentaje muy bajo", indica. Sin embargo, el valor que tienen las microalgas como materia prima para la industria farmacéutica o alimenticia sí que merecería la pena.
Con una planta solar en esta superficie se estima que se dejarían de emitir unas 200.000 toneladas de CO2, así que para disminuir el CO2, sería más conveniente apostar por las energías renovables, pero de cara al desarrollo de productos farmacéuticos, sería una idea muy ventajosa. "Bastantes empresas se están dedicando al mundo de las microalgas y están consiguiendo patentes", destaca Pedro José García.
FOTO: Una de las ventajas de las microalgas es que tienen gran capacidad de crecimiento.